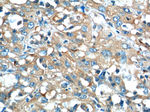
CEP164 Antibody in Immunohistochemistry (Paraffin) (IHC (P))

Search
Proteintech
CEP164 Polyclonal Antibody
{{$productOrderCtrl.translations['antibody.pdp.commerceCard.promotion.promotions']}}
{{$productOrderCtrl.translations['antibody.pdp.commerceCard.promotion.viewpromo']}}
{{$productOrderCtrl.translations['antibody.pdp.commerceCard.promotion.promocode']}}: {{promo.promoCode}} {{promo.promoTitle}} {{promo.promoDescription}}. {{$productOrderCtrl.translations['antibody.pdp.commerceCard.promotion.learnmore']}}

Please note: We are reviewing Western blot images included in the antibody testing data in our catalog, including those provided by third parties. Unless expressly labeled or annotated as “raw-unedited”, Western blot images included in the antibody testing data in our catalog may have been edited, optimized or otherwise adjusted for presentation.
产品信息
22227-1-AP
种属反应
已发表种属
宿主/亚型
分类
类型
抗原
偶联物
形式
浓度
规格
纯化类型
保存液
内含物
保存条件
运输条件
产品详细信息
Immunogen sequence: MAGRPLRIG DQLVLEEDYD ETYIPSEQEI LEFAREIGID PIKEPELMWL AREGIVAPLP GEWKPCQDIT GDIYYFNFAN GQSMWDHPCD EHYRSLVIQE RAKLSTSGAI KKK (1-112 aa encoded by BC000602)
靶标信息
CEP164 was initially identified as a centrosomal protein, but other studies have indicated that it also plays a role in the formation of primary cilia, the microtubule-based sensory antennae projecting from the surface of many eukaryotic cells as well as in DNA damage response acting as a mediator protein. CEP164 interacts with both ATR and ATM, proteins that trigger a number of cellular responses including the initiation of DNA damaged-induced cell cycle checkpoints. It is phosphorylated upon replication stress, ultraviolet (UV) radiation, and ionizing radiation silencing of CEP164 significantly reduces the DNA damage-induced phosphorylation of several proteins in the DNA damage-activated signaling cascade and compromises cell survival after UV damage. At least two isoforms of CEP164 are known to exist.
仅用于科研。不用于诊断过程。未经明确授权不得转售。
生物信息学
蛋白别名: ce164; Centrosomal protein of 164 kDa; Cep 164; Cep164
基因别名: CEP164; KIAA1052; NPHP15
Entrez Gene ID: (Dog) 489389




